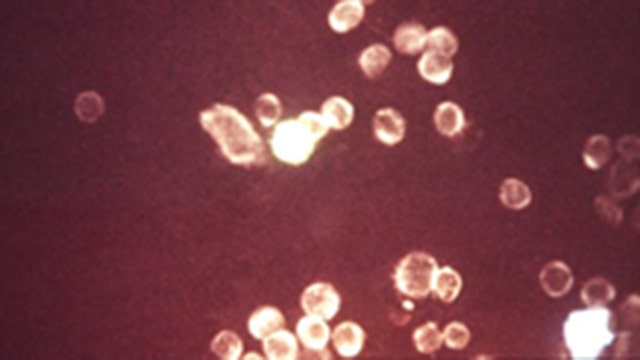
WHO: 3.7 billion people have herpes virus

Family's 'allergy-free Halloween' note goes viral
A Connecticut family's message to her neighbors has gone viral. Her son has a peanut allergy, so she asked everyone to "practice responsible parenting" and not hand out candy containing nuts, gluten, or dairy.
A Connecticut family's message to her neighbors has gone viral. Her son has a peanut allergy, so she asked everyone to "practice responsible parenting" and not hand out candy containing nuts, gluten, or dairy.
WHO: 3.7 billion people have herpes virus
If you are under 50, you likely have been exposed to the herpes virus, according to the World Health Organization . More than 3.7 billion people -- two-thirds of the world's population -- are infected with herpes simplex virus type 1, WHO researchers estimate. HSV-1 usually causes cold sores but it can also cause genital herpes.
If you are under 50, you likely have been exposed to the herpes virus, according to the World Health Organization . More than 3.7 billion people -- two-thirds of the world's population -- are infected with herpes simplex virus type 1, WHO researchers estimate. HSV-1 usually causes cold sores but it can also cause genital herpes.
EMT suspended for trying to save choking girl
A heroic New York EMT who tried in vain last week to save a 7-year-old school girl choking on her lunch said he was suspended because it is against company policy to make a stop without being called.
A heroic New York EMT who tried in vain last week to save a 7-year-old school girl choking on her lunch said he was suspended because it is against company policy to make a stop without being called.
Woman transforms 374-pound pumpkin into 'Donald Trumpkin'
An Ohio woman has transformed a 374-pound pumpkin into what she calls "Donald Trumpkin" for Halloween. Jeanette Paras is known for "pumpkinizing" celebrities and political figures every Halloween, her Facebook says.
An Ohio woman has transformed a 374-pound pumpkin into what she calls "Donald Trumpkin" for Halloween. Jeanette Paras is known for "pumpkinizing" celebrities and political figures every Halloween, her Facebook says.
Mother outraged after daughter is told 'God is a myth' at school
A school teacher from the Katy Independent School District tells her 7th grade students that God is a myth. That's according to 12-year-old Jordan Wooley, and corroborated by other students in the class.
A school teacher from the Katy Independent School District tells her 7th grade students that God is a myth. That's according to 12-year-old Jordan Wooley, and corroborated by other students in the class.
Watch a 1,465-pound pumpkin fall from 80 feet -- onto a minivan
Six months of hard work came crashing down for a man from northwestern Minnesota -- all for charity.
Six months of hard work came crashing down for a man from northwestern Minnesota -- all for charity.
Police use officer disguised as homeless man to catch drivers texting behind the wheel
Montgomery County police are using an interesting method to catch drivers they suspect of texting while behind the wheel.
Montgomery County police are using an interesting method to catch drivers they suspect of texting while behind the wheel.
Dog named Trigger shoots owner during waterfowl hunt
Authorities say a northern Indiana woman is recovering after being shot in the foot by her dog. And the dog's name? Trigger.
Authorities say a northern Indiana woman is recovering after being shot in the foot by her dog. And the dog's name? Trigger.
Dog lies down in road for hours at spot where Florida accident claimed his owner's life
A Florida woman was fatally struck by a big rig truck Friday and for hours afterward her dog remained at the scene, lying down in the road where the accident happened.
A Florida woman was fatally struck by a big rig truck Friday and for hours afterward her dog remained at the scene, lying down in the road where the accident happened.
Local News
The Most Popular Halloween Candy In Each State
Americans will spend more than $2-billion on candy this Halloween, but what’s the best candy to pass out in your state? Well, now we know.
Americans will spend more than $2-billion on candy this Halloween, but what’s the best candy to pass out in your state? Well, now we know.
Shocking video of baby smoking, drinking
Shocking video of baby smoking, drinking
Shocking video of baby smoking, drinking
Daily views of Earth available on 'EPIC' new website
A NOAA satellite is now offering daily 'blue marble' views of Earth.
A NOAA satellite is now offering daily 'blue marble' views of Earth.
Police seek road rager who shot, killed 4-year-old girl
Police are asking for the public's help as authorities try to identify and find an assailant who shot and killed a 4-year-old girl on an Albuquerque freeway.
Police are asking for the public's help as authorities try to identify and find an assailant who shot and killed a 4-year-old girl on an Albuquerque freeway.
Special fan scores memorable touchdown
It was a memorable night for football players and fans attending a game Thursday in Albany, Louisiana.
It was a memorable night for football players and fans attending a game Thursday in Albany, Louisiana.
Centuries-old church emerges from water
Centuries-old church emerges in water
Centuries-old church emerges in water
High School Football Player Stops During Game to Thank WWII Vets
A Louisiana high school football player shocked spectators during the middle of a game when he turned away from a team huddle to thank World War II veterans who were assembled on the sideline.
A Louisiana high school football player shocked spectators during the middle of a game when he turned away from a team huddle to thank World War II veterans who were assembled on the sideline.
Combat dog who earned Bronze Stars in Iraq shot and killed in Wyoming
A bomb-sniffing combat dog named Mike survived two tours of duty in Iraq, but not the streets of a bucolic little town in Wyoming.
A bomb-sniffing combat dog named Mike survived two tours of duty in Iraq, but not the streets of a bucolic little town in Wyoming.
Driver who admitted hitting motorcycle speaks out
GRANBURY, Texas (AP) — Authorities are investigating after a car veered into a motorcycle on a rural North Texas road in an incident that left two people injured and was captured on video. Eric Sanders, the driver of the motorcycle, contends the car's driver swerved intentionally. He suffered abrasions in the collision that left his girlfriend in a Fort Worth hospital with a broken wrist and deep arm lacerations.
GRANBURY, Texas (AP) — Authorities are investigating after a car veered into a motorcycle on a rural North Texas road in an incident that left two people injured and was captured on video. Eric Sanders, the driver of the motorcycle, contends the car's driver swerved intentionally. He suffered abrasions in the collision that left his girlfriend in a Fort Worth hospital with a broken wrist and deep arm lacerations.
Crews create heartwarming video for fellow firefighter with breast cancer
She’s been saving lives and fighting fires in Pasco County for almost 30 years, but as of recently, she’s had to concentrate on one fight in particular- the fight for her life.
She’s been saving lives and fighting fires in Pasco County for almost 30 years, but as of recently, she’s had to concentrate on one fight in particular- the fight for her life.